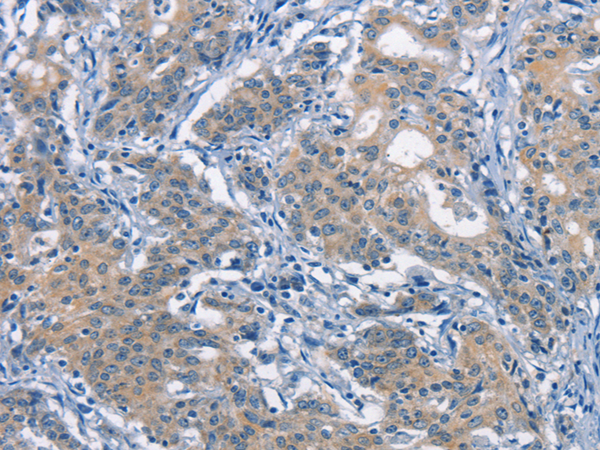

中文名稱:兔抗CDC25B 多克隆抗體
英文名稱: Anti-CDC25B rabbit polyclonal antibody
儲(chǔ) 存: 冷凍(-20℃)
宿 主: Rabbit
反應(yīng)種屬: Human, Mouse
標(biāo) 記 物: Unconjugate
克隆類型: rabbit polyclonal
技術(shù)規(guī)格
|
Background: |
CDC25B is a member of the CDC25 family of phosphatases. CDC25B activates the cyclin dependent kinase CDC2 by removing two phosphate groups and it is required for entry into mitosis. CDC25B shuttles between the nucleus and the cytoplasm due to nuclear localization and nuclear export signals. The protein is nuclear in the M and G1 phases of the cell cycle and moves to the cytoplasm during S and G2. CDC25B has oncogenic properties, although its role in tumor formation has not been determined. Multiple transcript variants for this gene exist. |
|
Applications: |
ELISA, WB, IHC |
|
Name of antibody: |
CDC25B |
|
Immunogen: |
Synthetic peptide of human CDC25B |
|
Full name: |
cell division cycle 25B |
|
SwissProt: |
P30305 |
|
ELISA Recommended dilution: |
5000-10000 |
|
IHC positive control: |
Human thyroid cancer and human gastric cancer |
|
IHC Recommend dilution: |
50-200 |
|
WB Predicted band size: |
65 kDa |
|
WB Positive control: |
RAW264.7 cells |
|
WB Recommended dilution: |
200-1000 |

購(gòu)物車
幫助
021-54845833/15800441009
